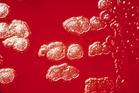
溶血性链球菌

-
溶血性链球菌 编辑
链球菌常根据其在血琼脂培养基上溶血环的大小,分为甲、乙、丙三型。 其中乙型溶血性链球菌具有完全的溶血性 ,菌落周围形成一个2-4mm宽、界限分明、完全透明的无色溶血环,这类细菌称为溶血性链球菌。
溶血性链球菌(Streptococcus hemolyticus)在自然界中分布较广,是一种常见的病原微生物,呈球形或椭圆形,直径0.6-1.0μm,呈链状排列,长短不一,从4-8个至20-30个菌细胞组成不等,链的长短与细菌的种类及生长环境有关。该菌不形成芽孢,无鞭毛,易被普通的碱性染料着色,革兰氏阳性,需氧或兼性厌氧菌,营养要求较高。
溶血性链球菌广泛存在于水、空气、尘埃、粪便及健康人和动物的口腔、鼻腔、咽喉中,可通过直接接触、空气飞沫或皮肤、黏膜伤口感染传播,而被污染的食品如奶、肉、蛋及其制品也会使人类感染,上呼吸道感染患者、人畜化脓性感染部位常成为食品污染的污染源。
溶血性链球菌,可引起皮肤和皮下组织的化脓性炎症、呼吸道感染,还可通过食品引起猩红热、流行性咽炎的暴发流行。 溶血性链球菌被列为食品卫生检验的主要对象之一。
中文名:溶血性链球菌
别名:β型溶血性链球菌
拉丁学名:Streptococcus hemolyticus
界:细菌界
纲:芽孢杆菌纲
目:乳杆菌目
科:链球菌科
属:链球菌属
链球菌常用的分类方法有根据溶血性、抗原结构等两种方法。
美国微生物学家Brown于1919年发现链球菌属不同菌种或菌株在血平板上可形成不同的溶血现象。 根据链球菌在血液培养基上生长繁殖后是否溶血及其溶血性质分为三类。
①α型(甲型)溶血性链球菌(α-hemolytic steptococcu):可引起不完全溶血现象,称甲型或α溶血。其菌落周围可形成1-2mm宽的草绿色溶血环,故这类细菌亦称草绿色链球菌(Srptococcus viridans),多为条件致病菌。 其中产生的溶血环为草绿色,是因为细菌产生的H2O2等氧化性的物质将血红蛋白氧化成高铁血红蛋白,绿色其实是高铁血红蛋白的颜色。
②β型(乙型)溶血性链球菌(β-hemolytic sreptococcs)可引起完全溶血现象,称乙型溶血或β溶血。其菌落周围形成-个2-4mm宽的透明溶血环,故这类细菌亦称溶血性链球菌(Srpococcus hemolyticus),致病力强,可引起人类和动物的多种疾病。
③γ-溶血链球菌(γ-streptococcus):不产生溶血素,菌落周围无溶血环,也称为丙型或不溶血性链球菌(Streptococcus non-hemolytics),该菌无致病性,常存在于乳类和粪便中,偶尔也引起感染。
1933年Lancefild根据链球菌细胞壁多糖抗原的不同,将其分为A、B、C、D四个群,其后不断发现和调整,目前分A-H、K-V共20群。其中,A.B、C群多为乙型溶血性链球菌,D群则为甲型溶血性链球菌或非溶血性链球菌。对人致病的,90%左右属A群, B、C、D、G群偶见,而其他各群的乙型溶血性链球菌主要引起家畜的感染。链球菌的群别与溶血性间无平行关系,但对人类致病的A群链球菌多数呈乙型溶血。 97%的A群链球菌可被杆菌肽抑制,其他链球菌则不被抑制。
溶血性链球菌
溶血性链球菌
一般来说,溶血性链球菌常通过以下途径污染食品 :
1、食品加工或销售人员口腔、鼻腔、手、面部有化脓性炎症时造成食品的污染;
2、食品在加工前就已带菌、奶牛患化脓性乳腺炎或畜禽局部化脓时,其奶和肉尸某些部位污染;
3、熟食制品因包装不善而使食品受到污染。
 溶血性链球菌
溶血性链球菌
大多数链球菌无鞭毛,不能运动,但D群和X群中某些菌株具有鞭毛。不能形成芽孢。多数链球菌在血清肉汤幼龄培养物(2-2.5h)中,易发现荚膜,当培养时间延长,荚膜即逐渐消失。
链球菌用普通苯胺染料易于着染,自病灶分离的链球菌为革兰阳性,但若长时间培养,或被吞噬细胞吞噬后,革兰染色常为阴性。
 溶血性链球菌
溶血性链球菌
分解葡萄糖,产酸不产气,对乳糖、甘露醇、水杨苷、山梨醇、棉子糖、蕈糖、七叶苷的分解能力因不同菌株而异。一般不分解菊糖,不被胆汁溶解,触酶阴性。
链球菌的抗原构造较复杂,主要有三种 :
(1)核蛋白抗原 或称P抗原,无特异性,各种链球菌均相同。
(2)多糖抗原 或称C抗原,系群特异性抗原,是细胞壁的多糖组分,可用稀盐酸等提取。
(3)蛋白质抗原 或称表面抗原,具有型特异性,位于C抗原外层,其中可分为M、T、R、S四种不同性质的抗原成分,与致病性有关的是M抗原。
溶血性链球菌常可引起皮肤、皮下组织的化脓性炎症,呼吸道感染、流行性咽炎的暴发性流行以及新生儿败血症、细菌性心内膜炎、猩红热、风湿热、肾小球肾炎等变态反应。链球菌食物中毒潜伏期较短(5-12h),临床症状较轻,表现为恶心、呕吐、腹痛、腹泻,1-2d即可恢复。溶血性链球菌的致病性与其产生的毒素及其侵袭性酶有关,主要有以下几种。
1、链球菌溶血素:溶血素有O和S两种,O为含有-SH的蛋白质,具有抗原性,S为小分子多肽,分子量较小,故无抗原性。
2、致热外毒素:曾称红疹毒素或猩红热毒素,是人类猩红热的主要毒性物质,会引起局部或全身红疹、发热、疼痛、恶心、呕吐、周身不适。
3、透明质酸酶:又称扩散因子,能分解细胞间质的透明质酸,故能增加细菌的侵袭力,使病菌易在组织中扩散。
4、链激酶:又称链球菌纤维蛋白溶酶,能使血液中纤维蛋白酶原变成纤维蛋白酶,具有增强细菌在组织中的扩散作用,该酶耐热,100℃50分钟仍可保持活性。
5、链道酶:又称链球菌DNA酶,能使脓液稀薄,促进病菌扩散。
6、杀白细胞素:能使白细胞失去动力,变成球形,最后膨胀破裂。
该菌抵抗力一般不强,60℃ 30min即被杀死,对常用消毒剂敏感,在干燥尘埃中生存数月。乙型链球菌对青霉素、红霉素、氯霉素、四环素、磺胺均敏感。青霉素是链球菌感染的首选药物,很少有耐药性。
1、样品处理:取25g固体(或25mL液体)检样加入225mL灭菌生理盐水,制成混悬液。
 溶血性链球菌
溶血性链球菌
3、链激酶试验:吸取草酸钾血浆0.2mL,加0.8mL灭菌生理盐水,混匀,再加入链球菌18-24h 36℃肉浸液肉汤培养物0.5mL及0.25%氯化钙0.25mL,混匀,置于36℃水浴10min,血浆混合物自行凝固,观察凝块重新完全溶解的时间,完全溶解为阳性,如24h后不溶解即为阴性。同时用肉浸液肉汤做阴性对照,用已知的链激酶阳性的菌株做阳性对照。
4、杆菌肽敏感试验:取典型菌落的菌液涂布于血平板上,用灭菌镊子夹取每片含有0.04单位的杆菌肽纸片置于上述平板上,36℃培养18-24h,如有抑菌圈出现即为阳性。用已知的阳性菌株做对照。
1、防止带菌人群对各种食物的污染,患局部化脓性感染、上呼吸道感染的人员要暂停与食品接触的工作。
2、防止对奶及其制品的污染,牛奶场要定期对生产中的奶牛进行体检,坚持挤奶前消毒,一旦发现患化脓性乳腺炎的奶牛要立即隔离,奶制品要用消毒过的原料,并注意低温保存。
3、在动物屠宰过程中,应严格执行检验法规,割除病灶并以流水冲洗;在肉制品加工过程中发现化脓性病灶应整块剔除。
截至2024年6月2日,日本2024年报告的相关病例多达977例,刷新此前历史纪录。 这种“食人细菌”引发的疾病为重症型溶血性链球菌感染(STSS),细菌从伤口进入后使感染部位坏死,进而患者出现多器官衰竭,感染后48小时即可致命,目前死亡率达10%~40%。
1、本站所有文本、信息、视频文件等,仅代表本站观点或作者本人观点,请网友谨慎参考使用。
2、本站信息均为作者提供和网友推荐收集整理而来,仅供学习和研究使用。
3、对任何由于使用本站内容而引起的诉讼、纠纷,本站不承担任何责任。
4、如有侵犯你版权的,请来信(邮箱:baike52199@gmail.com)指出,核实后,本站将立即删除。






























